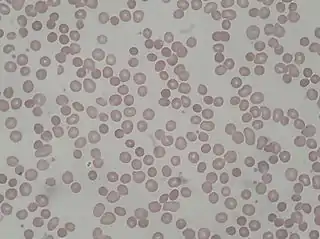

| Esferocitosis hereditaria | ||
|---|---|---|
![]() Frotis de sangre periférica de paciente con esferocitosis hereditaria | ||
| Especialidad | hematología | |
| Sinónimos | ||
| Anemia esferocítica congénita | ||
La esferocitosis hereditaria o anemia esferocítica congénita[1] es una enfermedad genética (75 % de los casos son autosómicos dominante y el otro 25 % corresponde a un patrón autosómico recesivo),[2] que forma parte de las llamadas anemias hemolíticas, caracterizada por la producción de hematíes (glóbulos rojos) de forma esferoidal, por un defecto en la membrana del mismo, lo cual hace que se destruya con facilidad en el bazo. Originalmente descrita por los profesores belgas Vanlair y Masius alrededor de 1870,[3] es la anemia hemolítica hereditaria más prevalente en la población.[4]
Causas
La esferocitosis hereditaria está causada por una variedad de mutaciones en los genes que transcriben para la espectrina[5] (el defecto más frecuente),[6] pero el más común es la deficiencia de anquirina. la ankirina (o anquirina), y otras proteínas de la membrana del hematíe.[7] Estas proteínas son necesarias para mantener la forma normal del hematíe, que es la de un disco bicóncavo. Estos defectos de membrana disminuyen en el glóbulo rojo su elasticidad y deformabilidad características y aumenta la concentración corpuscular media de hemoglobina (CCMH).[8] Como una de las funciones del bazo es eliminar aquellos hematíes de formas anormales (que generalmente son antiguos), también destruye los esferocitos.
| Tipo (Defecto). | Características[4] | Frecuencia |
|---|---|---|
| 1. Deficiencia de anquirina | Defecto de la transcripción. Mutaciones en región promotora Esferocitos y acidosis tubular |
40 al 50 % |
| 2. Deficiencia de banda 3 | Mutación de fragmento citoplasmático. Esferocitos y acidosis tubular |
20 al 30 % |
| 3. Deficiencia de espectrina | Mutación de codón de iniciación. Esquinocitos y acantocitos |
10 al 15 % |
| 4. Deficiencia de espectrina | Mutación puntual / gen lepra. Esferocitosis intensa |
5 al 10 % |
| 5. Deficiencia de proteína 4,2 | Mutaciones puntuales. Esferocitos. |
Frecuente en Japón. |
Síntomas
Generalmente comienza a los 5 o 6 años de edad, aunque puede presentarse en recién nacidos, de manera lenta, como una anemia crónica con ictericia (hiperbilirrubinemia no conjugada por hemólisis intravascular) y esplenomegalia (aumento del tamaño del bazo). También puede cursar con palidez, fatiga, debilidad, orina oscura, dolor abdominal, fiebre, cálculos biliares.[9] Las infecciones pueden desencadenar crisis hemolíticas y aplásicas.
Prevalencia
Se estima que la prevalencia es de 2.2 de cada 10 000 nacidos vivos, la mayoría heredados de sus padres. Un 25 % de los casos es debido a una neomutación.[10]
Diagnóstico
Mediante un análisis de sangre y la visualización de los hematíes al microscopio, el médico puede diagnosticar esta enfermedad. La fragilidad osmótica está característicamente elevada, esta prueba se realiza después del año de edad. La prueba de Coombs es generalmente negativa (–). Es también importante el fundamento de antecedentes familiares.
Tratamiento
Depende de la evolución, a veces son necesarias transfusiones de sangre para normalizar las cifras de hematíes, otras veces es necesaria una esplenectomía (extirpación del bazo) para controlar la enfermedad. En algunos casos se controla con ácido fólico o hierro.
Véase también
- Alteraciones de los hematíes
Referencias
- ↑ por MedlinePlus (julio de 2007). «Anemia esferocítica congénita». Enciclopedia médica en español. Consultado el 7 de julio de 2012.
- ↑ Herrera García, Mayelín; y Estrada Del Cueto, Marianela (2002): «Esferocitosis hereditaria: aspectos clínicos, bioquímicos y moleculares», artículo en la Revista Cubana de Hematología, Inmunología y Hemoterapia, vol. 18, n.º 1, pág. 0-0; enero-abril de 2002. ISSN 0864-0289.
- ↑ Vanclair; y Masius (1872): «Microcythoemia: a morbid condition of the blood hitherto undescribed», artículo en inglés en la revista Quarterly Journal of Microscopical Science, s2-12, págs. 296-300; 1872. Publicado en Journal of Cell Science (47).
- 1 2 «Anemias hemolíticas congénitas» Archivado el 25 de mayo de 2007 en Wayback Machine., artículo en "Síndromes anémicos (segunda parte)" en la revista Diagnóstico (Perú), volumen 44, número 3, julio-septiembre de 2005.
- ↑ OMIM (Online Medical Inheritence in Man): «Spherocytosis, type 1; SPH1» (enlace roto disponible en Internet Archive; véase el historial, la primera versión y la última)., completo artículo en inglés en el sitio web Omim.
- ↑ Cotran, R. S.; Kumar, V.; y Robbins, Stanley: Patología estructural y funcional, 6.ª edición.
- ↑ Arce Hernández, Ada Amalia; y Villaescusa Blanco, Rinaldo (2005): «Organización de la membrana celular: banda 3, estructura y función», artículo en español en la Revista Cubana de Hematología, Inmunología y Hemoterapia, vol. 21, n.º 3, págs. 0-0; septiembre-diciembre de 2005. ISSN 0864-0289.
- ↑ Vives Corronsa, J. L. (2001): «Anemias por alteraciones bioquímicas del eritrocito. Membranopatías y defectos del metabolismo» Archivado el 18 de noviembre de 2007 en Wayback Machine., artículo en la revista Medicine, volumen 8, número 51, págs. 2694-2702; 17 de septiembre de 2001.
- ↑ Artículo en inglés en la Enciclopedia Médica de Salud de la Biblioteca Nacional de Salud de Estados Unidos de América y los Institutos Nacionales de Salud.
- ↑ Online Medical Inheritence in Man: 182900 (HS)
Enlaces externos
- Manual Merck. Capítulo 154: Anemias